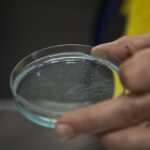

ACUICULTURA
Conocé el proceso

Captura
Los ejemplares reproductores se encuentran alojados en estanques bajo estricto control de agua y alimentación. El procedimiento de la captura se hace sin alarmar el cardumen para evitar que se dañen entre sí.
Posteriormente se saca cada ejemplar de manera cuidadosa y se los ubica en compartimientos separados, con agua climatizada y protegidos de la luz, para su traspaso a las piletas interiores.

Desove
Los reproductores que se extraen son analizados y seleccionados uno por uno para la extracción de los óvulos y espermas. Este delicado procedimiento se realiza en nuestro laboratorio especialmente diseñado para esta tarea con tecnología desarrollada por nuestros expertos. En la actualidad producimos millones de alevinos de las diferentes especies por año. Nuestros profesionales realizan la selección genética de los mejores ejemplares para la obtención de los huevos y del semen.

Cultivo
El desarrollo embrionario se realiza en salas de incubación que poseen sistemas de comunicación entre cubetas de gran tamaño con control de temperaturas y componentes del agua. Estos factores son fundamentales para garantizar una taza elevada de fecundación. Luego, en instalaciones especiales, se induce al desove y a la fecundación de los huevos con el semen seleccionado. Se hace el seguimiento y análisis de la fecundación y las larvas nacen en incubadoras especiales. Durante este paso, que dura 30 días, se suministra alimento natural pulverizado.

Aguas
La calidad del agua proviene de vertientes naturales del establecimiento. Es mantenida y controlada en nuestros laboratorios y con ella renovamos constantemente los estanques. Ésto garantiza un rápido crecimiento en buen estado sanitario para ofrecer la calidad que nos destaca y un sabor inmejorable.

Alimentación
La alimentación se cumple hasta la madurez y peso total del ejemplar. El suministro de alimento no debe perder sus propiedades al entrar en contacto con agua, como tampoco debe sumergirse para evitar que los ejemplares ingieran el alimento desde el fondo. Los peces crecen en estanques que están adecuados a las condiciones de su hábitat natural y son alimentados con dietas balanceadas obtenidas en nuestro establecimiento a partir de materias primas de primerísima calidad.
Conocé el proceso de Acuicultura
NUESTRO PRODUCTO PREPARADO